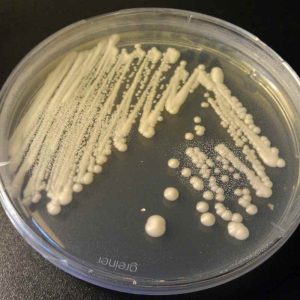
Boosting Fertility in Livestock with Yeast Culture in Feed

Supporting Digestive Health in Livestock with Yeast Culture
449A healthy gut is the foundation of strong livestock performance. Yeast culture plays a crucial role in maintaining digestive health in animals, ensuring they can effectively absorb nutrients from t...
View details Animal Feed Yeast-Yeast culture manufacturers
Animal Feed Yeast-Yeast culture manufacturers